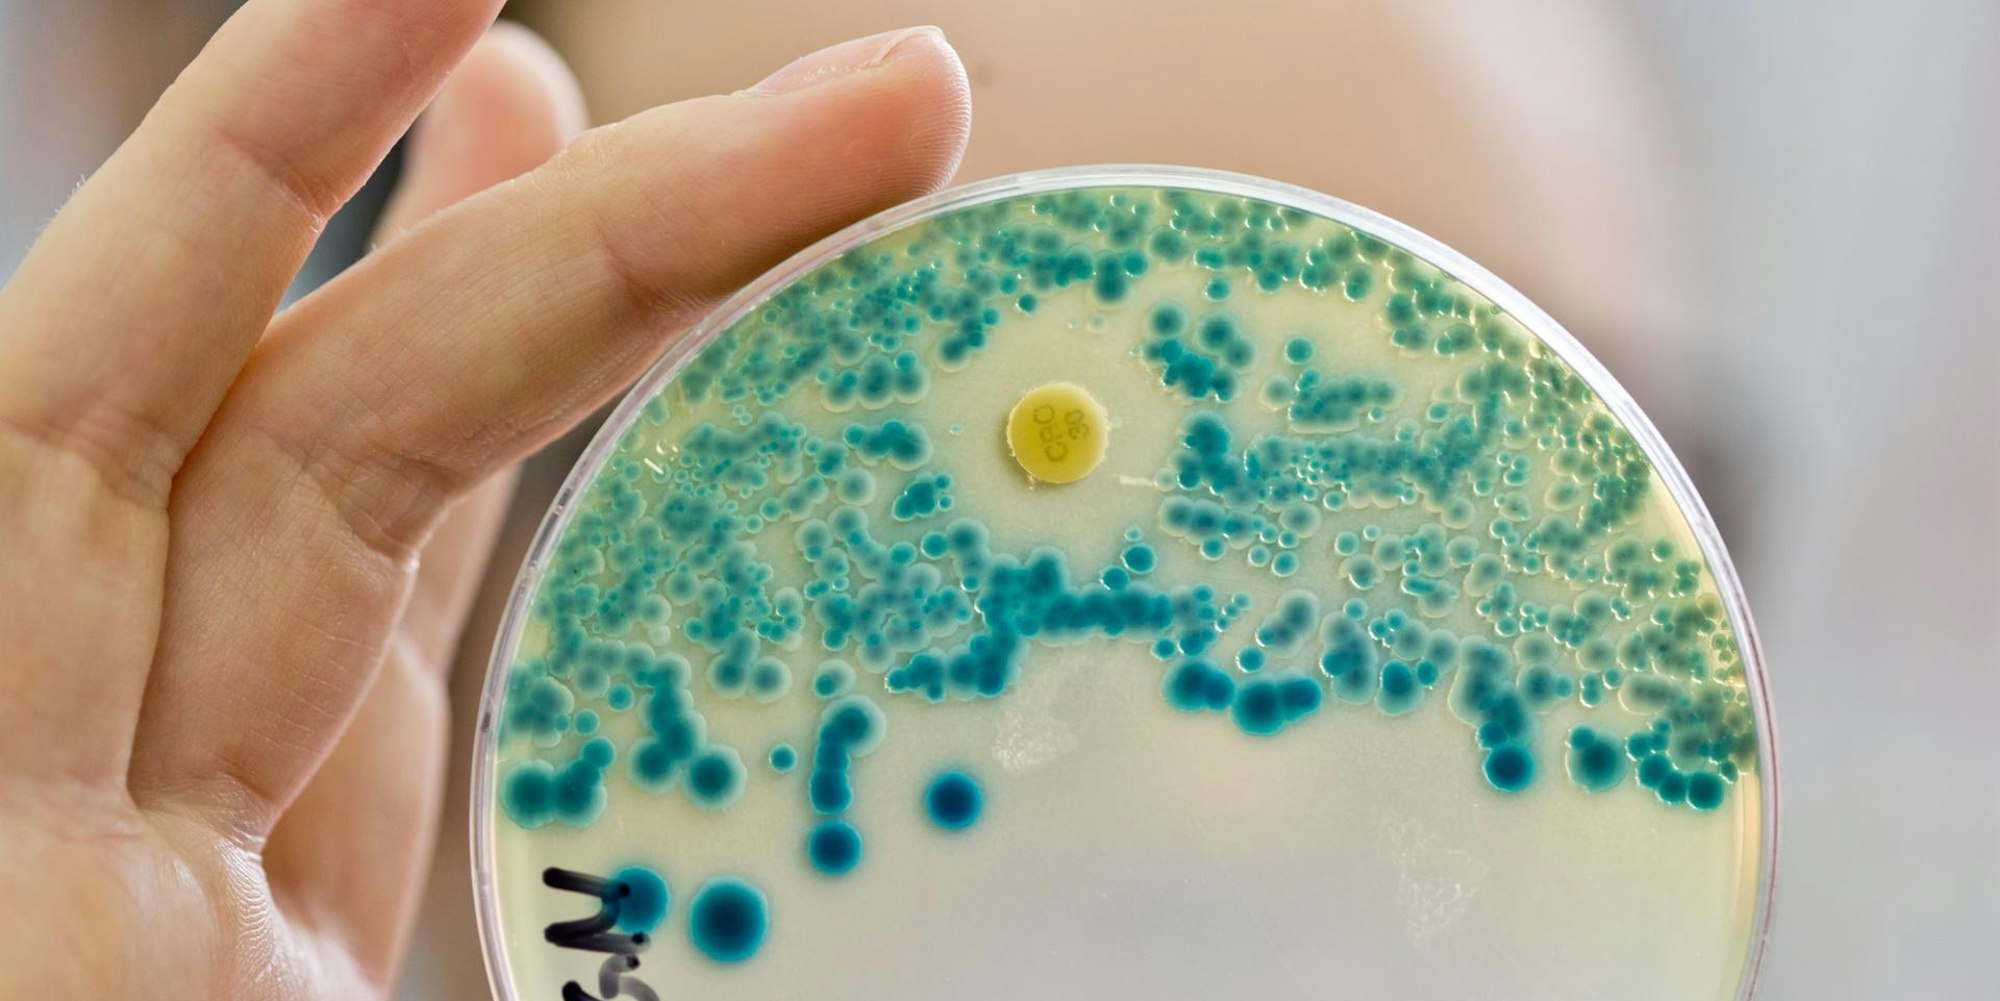
Multiresistente Keime (Symbol)

Multiresistente KeimeKreisverwaltung stellt Gesundheitsamt kritisches Zeugnis aus
Das Gesundheitsamt kontrolliert Arztpraxen und Schwimmbäder zu selten auf multiresistente Keime. (Symbolfoto)
Copyright: picture alliance/dpa
Rhein-Sieg-Kreis – Viele Arztpraxen in der Region, aber auch Schwimmbäder und Trinkwasseranlagen werden offenbar nur unzureichend auf multiresistente Keime und andere Gesundheitsgefahren untersucht. Das ist eines der Ergebnisse einer internen Untersuchung der Kreisverwaltung.
Das Prüfungsamt des Kreises bescheinigt dem für Gesundheitsdienstleistungen und Hygieneüberwachung zuständigen Amt 53 in seinem nichtöffentlichen Jahresprüfungsbericht 2018, dass verschiedene Vorschriften wie die Trinkwasserverordnung und das Infektionsschutzgesetz (IfSG) nur unzureichend befolgt werden.
Kreis kann Dreijahres-Rhythmus nicht einhalten
Das nordrhein-westfälische Gesetz über den öffentlichen Gesundheitsdienst und das Infektionsschutzgesetz sehen eigentlich vor, dass Einrichtungen des Gesundheitswesens aus hygienischer Sicht überwacht werden müssen – vor allen jene, in denen es durch Blutübertragungen zur Übertragung von Infektionen kommen kann. Unter anderem für kleine Privatkliniken, Tageskliniken sowie nicht operierende Arzt- und Zahnarztpraxen – Einrichtungen der Risikoklasse B – sind Hygienebegehungen im Dreijahres-Rhythmus vorgeschrieben. Das kann der Kreis allerdings nicht leisten. „Das Kreisgesundheitsamt überprüft Arztpraxen und Zahnarztpraxen im Rhein-Sieg-Kreis nur anlassbezogen, was nicht der 2013 geänderten Risikoklassifizierung (. . .) entspricht“, heißt es im Prüfbericht.
Immerhin im Abstand von einem bis zu fünf Jahren sollten Einrichtungen der Risikogruppe C Besuch von Gesundheitsamt bekommen. Dazu gehören etwa Schulen und Kindergärten. Auch das passiert aber offenkundig nicht. Auch bei diesen Einrichtungen werde bislang nur anlassbezogen kontrolliert.
Trinkwasser in Risikoklasse-A-Einrichtungen wird nicht überwacht
Defizite gibt es laut Prüfungsamt auch bei der Überwachung des Trinkwassers in Einrichtungen der Risikoklasse A – Krankenhäuser, ambulant operierende Arztpraxen, Dialyseeinrichtungen sowie Altern- und Pflegeheime – wo unter anderem das Auftreten des Krankenhauskeims Pseudomonas aeruginosa verhindert werden soll. „In den letzten Jahren erfolgte weder eine regelmäßige Überwachung von zumindest Einrichtungen der Risikoklasse A hinsichtlich des Auftretens der Erregers Pseudomonas aeruginosa im Trinkwasser, noch eine regelmäßige Überwachung der Neuinstallationen von Brauchwasser- bzw. Regennutzungsanlagen“, heißt es dazu im Bericht.
Dass solche Überwachungen aber dringend erforderlich sind, zeigen die Erfahrungen, die das Gesundheitsamt bei den wenigen anlassbezogenen Ermittlungen macht. Dort stoße man immer wieder auf Anlagen, „die nicht regelkonform von der regulären Trinkwasserversorgung getrennt sind und auf diese Weise Eintrittsorte für Krankheitserreger oder andere gar toxische Substanzen bieten können“, so die Prüfer.
Über Zuständigkeiten gebe es Diskussionsbedarf
Dass der Rhein-Sieg-Kreis die eigentlich nötigen Überprüfungen zumindest im vergangenen Jahr nicht eingehalten hat, räumt Pressesprecherin Rita Lorenz ein. Die Gründe dafür seien mehrschichtig und nicht so einfach zu benennen. Personell sei das Amt gut aufgestellt. Über Zuständigkeiten gebe es Diskussionsbedarf.
Der Prüfbericht werde im Fachamt ernst genommen und auch geprüft, was verbessert werden könne. Eine höhere Gefahr durch multiresistente Keime sieht Lorenz nicht. Der Kreis werde per Gesetz von den untersuchenden Laboren über jedes auffällige Ergebnis informiert, egal ob es sich um eine Blutuntersuchung nach einem Unfall oder um eine Probe aus einer Trinkwasseranlage handle.
Kritische Untersuchungsergebnisse gingen direkt an den Kreis
Selbst Proben zu nehmen sei nicht Aufgabe des Kreises. Diese müssten die Betreiber von Praxen, Kliniken oder anderen Einrichtungen regelmäßig selbst an die Labore geben. Geschehe das nicht, drohe ein Bußgeld. Kritische Untersuchungsergebnisse wiederum gingen direkt auch an den Kreis. Darüber hinaus gehöre der Kreis dem MRE-Netz Regio Rhein-Ahr an, das regelmäßig Arztpraxen und andere Einrichtungen bei der Prävention schule, sagte Lorenz. Die Abkürzung steht für „multiresistente Erreger“.
Im Fokus des internen Prüfberichts stehen auch Schwimmbäder. Konnten bereits seit 2001 nicht mehr alle Schwimmbäder kontrolliert werden, sondern nur noch die öffentlich betriebenen, so sei auch dies nicht mehr möglich. „Inzwischen können – laut Aussage des Fachbereichs – auch die öffentlich betriebenen Schwimmbäder nicht mehr vollständig überwacht werden“, so der Befund.
Diese Dinge laufen im Kreis gut
Neben dieser Vielzahl von Defiziten kommt der interne Bericht aber auch zu positiven Befunden. So kann das Gesundheitsamt alle Pflichtaufgaben im Bereich der meldepflichtigen Infektionskrankheiten – unter anderem Masern, Hepatitis A, EHEC sowie MRSA-Bakterien bei Blutvergiftungen und Hirnhautentzündungen – „stets vollumfänglich“ erfüllen. Gleiches wird der Behörde bei der Tuberkulosefürsorge bescheinigt.
